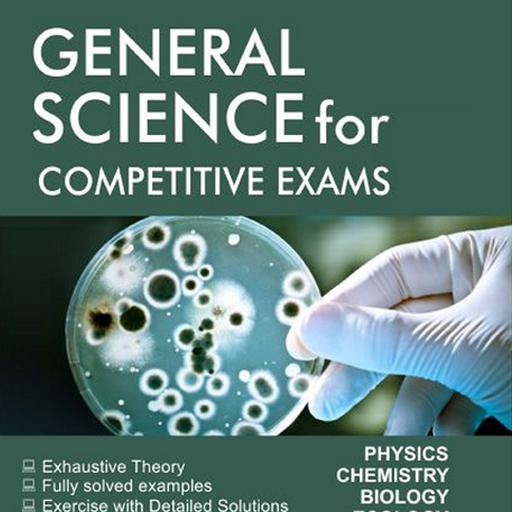
General Science for Competitive Exams OFFLINE иконка

CONTENTS
**********************PHYSICS**********************
1. Mechanics
2. Properties of matter
3. Heat
4. Sound
5. Optics
6. Electricity
7. Magnetism
8. Semiconductor Electronics
**********************CHEMISTRY**********************
1. Nature of Matter
2. Structure of Atom
3. Classification of Elements and Periodicity in Properties
4. Acids, Bases and Salts
5. Metals & Non-Metals
6. Environmental Pollution
7. General Concepts of Chemistry
8. Some Important Man-Made Materials
9. General Organic Chemistry
**********************BIOLOGY**********************
1. Diversity in Living Organisms
2. Cells and Tissues
3. Plant Physiology
4. Human Physiology
5. Genetics and Evolution
6. Biology in Human Welfare
7. Diseases and their defence mechanism
8. Ecology & Environment Awareness




